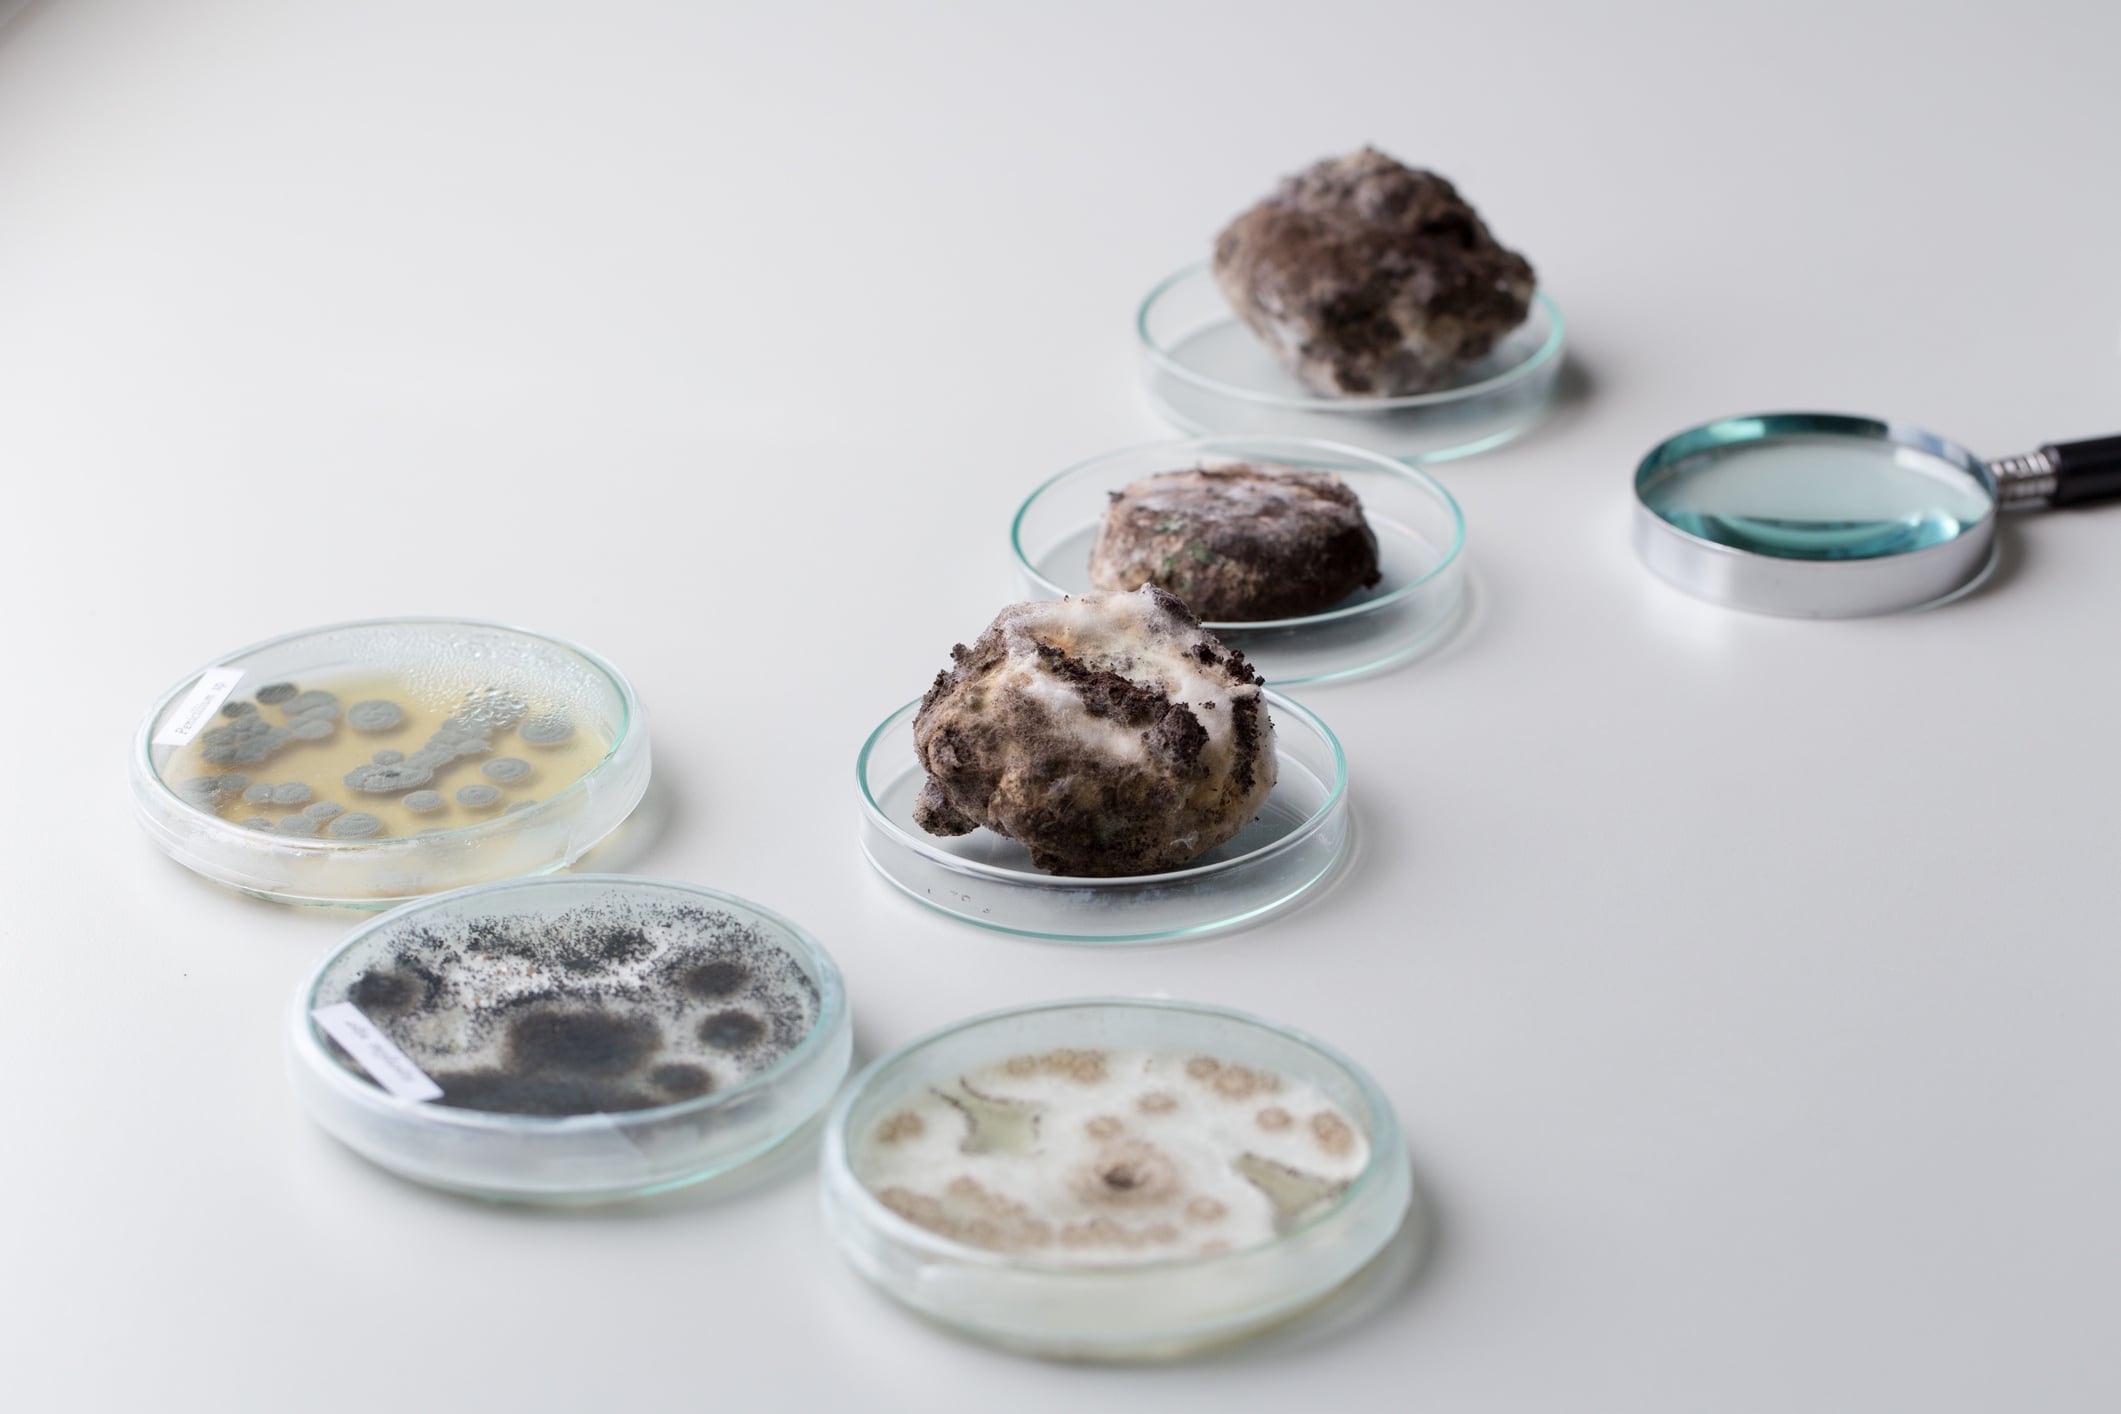
Asperillus niger in petri dish

Key takeaways:
- Two separate lawsuits allege Cape Cod Chips misled consumers by claiming ‘no artificial preservatives’ while using synthetic, mold-fermented citric acid.
- The cases challenge how food companies use ‘natural’ and clean label claims in a market where nearly all citric acid is produced synthetically.
- A ruling against Campbell’s could force widespread label changes, reformulations or stricter marketing language across the snack industry.
Cape Cod’s picturesque lighthouse packaging has long sold a sense of simple, New England purity. But that clean label glow is now under pressure from two lawsuits arguing the chips aren’t quite as natural as the bag suggests.
On October 23, plaintiff Rozaliya Ripa hauled The Campbell’s Company into New York federal court, alleging the snack maker misled shoppers with its ‘No Artificial Colors, Flavors or Preservatives’ claim while using synthetic citric acid across a wide spread of Cape Cod varieties. The complaint cites the US Department of Agriculture in asserting that naturally derived, fruit-extracted citric acid is “no longer commercially available.” That doesn’t mean citric acid itself is rare – it’s used everywhere – but that almost all commercially produced citric acid is made through fermentation with Aspergillus niger, a black mold, rather than extracted from citrus. The plaintiffs argue this production method makes the ingredient synthetic and therefore at odds with Cape Cod’s clean label promise.
Ripa says she bought the chips “numerous times” believing the front-of-pack claim meant what it said, and had she known the true nature of the ingredient, she “would not have purchased the Products or would have only been willing to purchase the Products at a lesser price.”
This isn’t the brand’s first brush with the citric acid debate. On July 7, plaintiff Jaqueline Dushaj filed a separate lawsuit arguing that 11 Cape Cod products marketed as free from artificial flavors and preservatives actually contained the additive. She said such claims “induce health-conscious consumers” to pay a premium believing the chips are preservative-free. Her complaint alleges Campbell’s profits unduly from that perception. And this isn’t unique to Cape Cod: PepsiCo was hit with a similar suit this year over citric acid in its Poppables.
These actions have turned a normally unremarkable ingredient line into a flashpoint for what ‘natural’ means in a food system where nearly all citric acid is produced the same way.
Why citric acid sits at the center of the storm
Citric acid is one of the most ubiquitous ingredients in processed foods. It brightens flavor, stabilizes pH, slows oxidation and extends shelf life. That multifunctional role is exactly why plaintiffs say it conflicts with ‘no artificial preservatives’ claims. Even if it’s added primarily for flavor, they argue, citric acid acts as a preservative and its synthetic production should disqualify a product from clean label promises.
The lawsuits describe its manufacture as a high-volume industrial fermentation process in which A. niger feeds on sugar to produce the acid. It’s safe, efficient and widely used, but it doesn’t resemble the citrus-derived ingredient consumers picture when they imagine ‘natural’. The filings also point to older FDA warning letters from 2001 that advised companies not to use ‘all natural’ claims on foods containing citric acid. Those letters aren’t binding, but they do add historical texture to the argument that the line between natural and synthetic isn’t as blurry as modern marketing makes it appear.
So far, Campbell’s isn’t engaging publicly. Its only statement has been the standard corporate line: “The company declines to comment on this pending litigation,” along with an assurance that Cape Cod chips are made with “high quality, carefully selected ingredients.”
Meanwhile, the clean label market has never been more lucrative. Grand View Research valued the US healthy snack segment at $31.9bn in 2024 and expects it to surge to $54.6bn by 2033. Consumers are increasingly willing to pay more for snacks that appear minimally processed and free from artificial additives. The lawsuits argue Campbell’s leveraged that willingness by making promises that don’t hold up under scrutiny.
Clean label confusion

If the court agrees that synthetic citric acid undermines a ‘no artificial preservatives’ claim, the consequences won’t be limited to Cape Cod. Nearly every major snack maker uses citric acid somewhere in its portfolio. A ruling for the plaintiffs could force sweeping label revisions, reformulations or at least stricter wording. Something as small as shifting from ‘no artificial preservatives’ to ‘no added artificial preservatives’ can significantly reduce legal exposure, but doing so dulls the marketing power that helps premium chip brands command higher prices.
The lawsuits also push the food industry back toward an old debate: does ‘natural’ refer to an ingredient’s source, how it’s processed or how it functions in a finished product? The FDA has never defined the term, leaving brands to interpret it in ways that suit their positioning.
That regulatory gap is precisely what these lawsuits are designed to exploit. The plaintiffs claim the combination of synthetic origin and preservative function contradicts Cape Cod’s core marketing message. Campbell’s will likely argue that the ingredient is widely accepted, safe and added for flavor, not preservation, and that consumers don’t interpret the claim as strictly as the plaintiffs insist.
But the implications go well beyond semantics. Premium snack brands trade on trust. Cape Cod’s appeal isn’t just crunch; it’s the perception of being a cleaner alternative. If shoppers begin to doubt the credibility of ‘no artificial’ claims, they may drift toward cheaper private label chips, which rarely make such promises. Retailers might welcome the shift, but national brands wouldn’t.
There’s also the question of reformulation. Producing a truly natural, fruit-extracted citric acid at commercial scale would be expensive and technically challenging, and many manufacturers may decide it isn’t viable. Others could soften their language, adopting fuzzier claims that still imply healthfulness while dodging legal scrutiny. If past clean label litigation is any guide, these cases won’t just alter packaging; they will reshape how the industry talks about naturalness.
This case is still in its early stages. An initial conference is scheduled for December, the class hasn’t been certified and Campbell’s hasn’t filed a detailed response. But both lawsuits lay out the same core accusation: that Cape Cod “markets its products in a systematically misleading manner by misrepresenting that the products do not contain preservatives.” Whether the court accepts that framing will affect not just this brand, but any product built on similar claims.
A settlement remains a likely outcome – most clean label class actions resolve before trial – but settlements often force changes in either labeling or marketing practices. And if the court sides with the plaintiffs, the ruling could be used as ammunition against a long list of products across snacks, beverages and baked goods. At stake is whether the industry has stretched the meaning of ‘natural’ and ‘clean’ beyond what regulators – or consumers – will accept.
The cases are Ripa v. The Campbell’s Company, Case No. 1:25-cv-05921, in the US District Court for the Eastern District of New York; and Dushaj v. The Campbell’s Company, Case No. 7:25-cv-05572, filed July 7, 2025, in the US District Court for the Southern District of New York.



